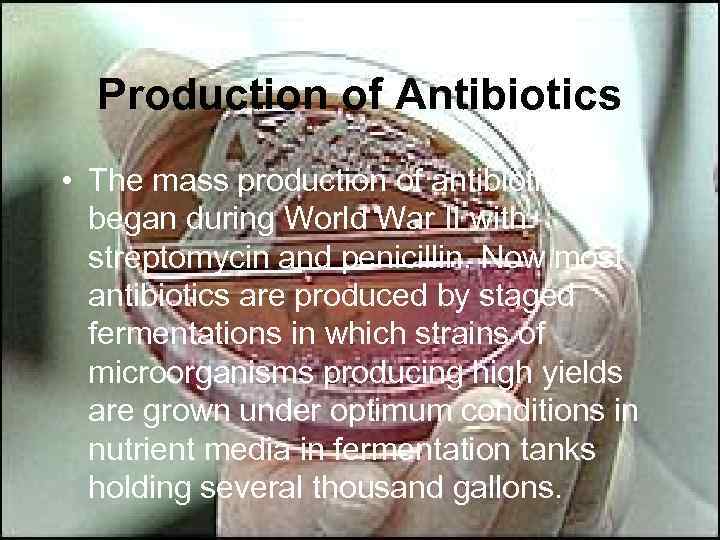
Production of Antibiotics • The mass production of antibiotics began during World War II

Antibiotics (2).ppt
- Количество слайдов: 32

Antibiotics By Konrad T. Juszkiewicz, MD, MPH

Overview • If bacteria make it past our immune system and start reproducing inside our bodies, they cause disease. • Certain bacteria produce chemicals that damage or disable parts of our bodies. • Antibiotics work to kill bacteria. Antibiotics are specific to certain bacteria and disrupt their function.


Antibiotics overview • An antibiotic is a selective poison. • It has been chosen so that it will kill the desired bacteria, but not the cells in your body. • Each different type of antibiotic affects different bacteria in different ways. • For example, an antibiotic might inhibit a bacteria's ability to turn glucose into energy, or the bacteria's ability to construct its cell wall. Therefore the bacteria dies instead of reproducing.

History • Although for centuries preparations derived from living matter were applied to wounds to destroy infection, the fact that a microorganism is capable of destroying one of another species was not established until the latter half of the 19 th cent. when… • Pasteur noted the antagonistic effect of other bacteria on the anthrax organism and pointed out that this action might be put to therapeutic use.

History • Meanwhile the German chemist Paul Ehrlich developed the idea of selective toxicity: – that certain chemicals that would be toxic to some organisms, e. g. , infectious bacteria, would be harmless to other organisms, e. g. , humans. • In 1928, Sir Alexander Fleming, a Scottish biologist, observed that Penicillium notatum, a common mold, had destroyed staphylococcus bacteria in culture.

History • In 1939 the American microbiologist René Dubos demonstrated that a soil bacterium was capable of decomposing the starchlike capsule of the pneumococcus bacterium, without which the pneumococcus is harmless and does not cause pneumonia. • Dubos then found in the soil a microbe, Bacillus brevis, from which he obtained a product, tyrothricin, that was highly toxic to a wide range of bacteria. • Tyrothricin, a mixture of the two peptides gramicidin and tyrocidine, was also found to be toxic to red blood and reproductive cells in humans but could be used to good effect when applied as an ointment on body surfaces.

History • Penicillin was finally isolated in 1939, and • in 1944 Selman Waksman and Albert Schatz, American microbiologists, isolated streptomycin and a number of other antibiotics from Streptomyces griseus.


Mechanism of action • Most antibiotics act by selectively interfering with the synthesis of one of the large-molecule constituents of the cell—the cell wall or proteins or nucleic acids. • Some, however, act by disrupting the cell membrane. • Some important and clinically useful drugs interfere with the synthesis of peptidoglycan, the most important component of the cell wall. • These drugs include the -lactam antibiotics, which are classified according to chemical structure into penicillins, cephalosporins, and carbapenems .

Penicilin • All penicillin like antibiotics inhibit synthesis of peptidoglycan, an essential part of the cell wall. • They do not interfere with the synthesis of other intracellular components. • The continuing buildup of materials inside the cell exerts ever greater pressure on the membrane, which is no longer properly supported by peptidoglycan. • The membrane gives way, the cell contents leak out, and the bacterium dies. • These antibiotics do not affect human cells because human cells do not have cell walls .

Mechanism of action • Many antibiotics operate by inhibiting the synthesis of various intracellular bacterial molecules, including DNA, RNA, ribosomes, and proteins. • The synthetic sulfonamides are among the antibiotics that indirectly interfere with nucleic acid synthesis. • Some antibacterials affect the assembly of messenger RNA, thus causing its genetic message to be garbled. • When these faulty messages are translated, the protein products are nonfunctional

Other mechanism of action • The tetracyclines compete with incoming transfer-RNA molecules; • the aminoglycosides cause the genetic message to be misread and a defective protein to be produced; • chloramphenicol prevents the linking of amino acids to the growing protein; • puromycin causes the protein chain to terminate prematurely, releasing an incomplete protein.


Clasification • According to their action against the infecting organism. • Some antibiotics attack the cell wall; • Some disrupt the cell membrane; • The majority inhibit the synthesis of nucleic acids and proteins, • The polymers that make up the bacterial cell.

Classification • Another method classifies antibiotics according to which bacterial strains they affect: staphylococcus, streptococcus, or Escherichia coli, for example. Antibiotics are also classified on the basis of chemical structure, as penicillins, cephalosporins, aminoglycosides, tetracyclines, macrolides, or sulfonamides, among others.

Administration and Side Effects • Antibiotics are either injected, given orally, or applied to the skin in ointment form. Many, while potent anti-infective agents, also cause toxic side effects. Some, like penicillin, are highly allergenic and can cause skin rashes, shock, and other manifestations of allergic sensitivity. Others, such as the tetracyclines, cause major changes in the intestinal bacterial population and can result in superinfection by fungi and other microorganisms.
Production of Antibiotics • The mass production of antibiotics began during World War II with streptomycin and penicillin. Now most antibiotics are produced by staged fermentations in which strains of microorganisms producing high yields are grown under optimum conditions in nutrient media in fermentation tanks holding several thousand gallons.

• The mass production of antibiotics began during World War II with streptomycin and penicillin. • Now most antibiotics are produced by staged fermentations in which strains of microorganisms producing high yields are grown under optimum conditions in nutrient media in fermentation tanks holding several thousand gallons.


Production of Antibiotics • The mold is strained out of the fermentation broth, and then the antibiotic is removed from the broth by filtration, precipitation, and other separation methods. • In some cases new antibiotics are laboratory synthesized, while many antibiotics are produced by chemically modifying natural substances; • many such derivatives are more effective than the natural substances against infecting organisms or are better absorbed by the body, e. g. , some semisynthetic penicillins are effective against bacteria resistant to the parent substance.

Production • The production of a new antibiotic is lengthy and costly. • First, the organism that makes the antibiotic must be identified and the antibiotic tested against a wide variety of bacterial species. • Then the organism must be grown on a scale large enough to allow the purification and chemical analysis of the antibiotic and to demonstrate that it is unique. • This is a complex procedure because there are several thousand compounds with antibiotic activity that have already been discovered, and these compounds are repeatedly rediscovered.

Production • After the antibiotic has been shown to be useful in the treatment of infections in animals, larger-scale preparation can be undertaken. • Commercial development requires a high yield an economic method of purification. • Extensive research may be needed to increase the yield by selecting improved strains of the organism or by changing the growth medium. • The organism is then grown in large steel vats, in submerged cultures with forced aeration. The naturally fermented product may be modified chemically to produce a semisynthetic antibiotic.

Production • After purification, the effect of the antibiotic on the normal function of host tissues and organs (its pharmacology), and… • Its possible toxic actions (toxicology), must be tested on a large number of animals of several species. • In addition, the effective forms of administration must be determined. .

Production • Once these steps have been completed, the manufacturer may file an Investigational New Drug Application with the Food and Drug Administration (FDA). • If approved, the antibiotic can be tested on volunteers for toxicity, tolerance, absorption, and excretion. • If subsequent tests on small numbers of patients are successful, the drug can be used on a larger group, usually in the hundreds. • If all goes well the drug can be used in clinical medicine. These procedures, from the time the antibiotic is discovered in the laboratory until it undergoes clinical trial, usually extend over several years.

Risks and Limitations • The use of antibiotics is limited because bacteria have evolved defenses against certain antibiotics. • One of the main mechanisms of defense is inactivation of the antibiotic. • This is the usual defense against penicillins and chloramphenicol, among others. • Another form of defense involves a mutation that changes the bacterial enzyme affected by the drug in such a way that the antibiotic can no longer inhibit it. • This is the main mechanism of resistance to the compounds that inhibit protein synthesis, such as the tetracyclines.

Resistance • All these forms of resistance are transmitted genetically by the bacterium to its progeny. • Genes that carry resistance can also be transmitted from one bacterium to another by means of plasmids, chromosomal fragments that contain only a few genes, including the resistance gene. • Some bacteria conjugate with others of the same species, forming temporary links during which the plasmids are passed from one to another. • Animation

Resistance • If two plasmids carrying resistance genes to different antibiotics are transferred to the same bacterium, their resistance genes can be assembled onto a single plasmid. • The combined resistances can then be transmitted to another bacterium, where they may be combined with yet another type of resistance. • In this way, plasmids are generated that carry resistance to several different classes of antibiotic. • In addition, plasmids have evolved that can be transmitted from one species of bacteria to another, and these can transfer multiple antibiotic resistance between very dissimilar species of bacteria.

Resistance • The problem of resistance has been exacerbated by the use of antibiotics as prophylactics, intended to prevent infection before it occurs. • Indiscriminate and inappropriate use of antibiotics for the treatment of the common cold and other common viral infections, against which they have no effect, removes antibiotic-sensitive bacteria and allows the development of antibiotic-resistant bacteria. • Similarly, the use of antibiotics in poultry and livestock feed has promoted the spread of drug resistance and has led to the widespread contamination of meat and poultry by drug-resistant bacteria such as Salmonella.

Resistance • Some bacteria, particularly strains of plasmodia, the causative organisms of malaria, have developed resistance to antibiotics, while, at the same time, the mosquitoes that carry plasmodia have become resistant to the insecticides that were once used to control them. • Consequently, although malaria had been almost entirely eliminated, it is now again rampant in Africa, the Middle East, Southeast Asia, and parts of Latin America.

Resistance • Similarly, staphylococci, are resistant to so many classes of antibiotics that the infections they cause are almost untreatable. • When such a strain invades a surgical ward in a hospital, it is sometimes necessary to close the ward altogether for a time. • Concerns are increasing as resistance to even the most powerful antibiotics (e. g. , vancomycin) has begun to appear. • Although drug companies are again concentrating on antibiotic research, no new products are expected until

Assignment • What is selective toxicity and how does it apply to the use of gramicidin? • Explain the process associated with the production of a new antibiotic? • Under what basis are antibiotics classified? • What are some of the causes for bacterial resistance? • Explain two methods by which bacteria gain resistance to antibiotics. • Describe 3 mechanisms used by antibiotics to kill bacteria.
Antibiotics (2).ppt